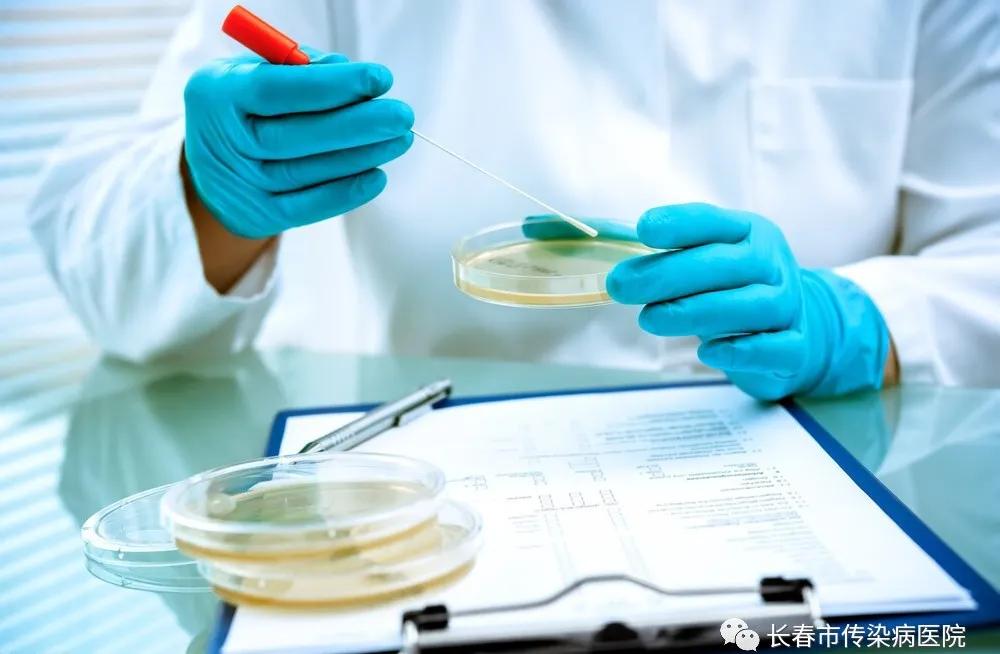
微生物手工报告单怎么看,微生物化验单怎么看

医生简介

王珏,*共中***党**员,主管检验师。
毕业于北华大学医学检验专业,硕士学历,长春市传染病医院检验科微生物组组长,荣获吉林省结核病实验室技术标兵称号!
何为微生物的感染?
大到2003年的非典;2020年的新冠。
小到我们日常感冒、发烧、咳嗽、腹泻等。
都是由于微生物的感染导致我们“中招”。
面对”诡计多端“的微生物,医护人员应该做到精准诊断,及时治疗。微生物培养,可发现致病菌,鉴定出菌名,提供药敏报告单,指导临床用药。

药敏试验报告中
S、I、R 、SDD指的是什么?
S-Susceptible敏感,常规剂量通常有效,即使用标准给药方案
I :intermediate(中介)意味着药物在生理浓集的部位具有临床效力,可用高于正常剂量的药物进行治疗。
R-Resistant(耐药),常规剂量治疗无效。
SDD-susceptible-DoseDependent(剂量依赖性敏感)
分离株的敏感性依赖于对患者的给药方案,为使血药浓度达到临床疗效,可提高剂量、增加用药频率,或二者皆有,可考虑给予最大许可剂量。
药敏试验结果
与临床抗菌药物的选择?
有些药物体外敏感,体内不敏感,要看具体细菌,也要看MIC值,应选择远离“S”折点的MIC值。药敏结果都敏感时,药物的选择也看感染部位,比如有的药在肝胆部位浓度高,有些能通过血脑屏障,等等。
